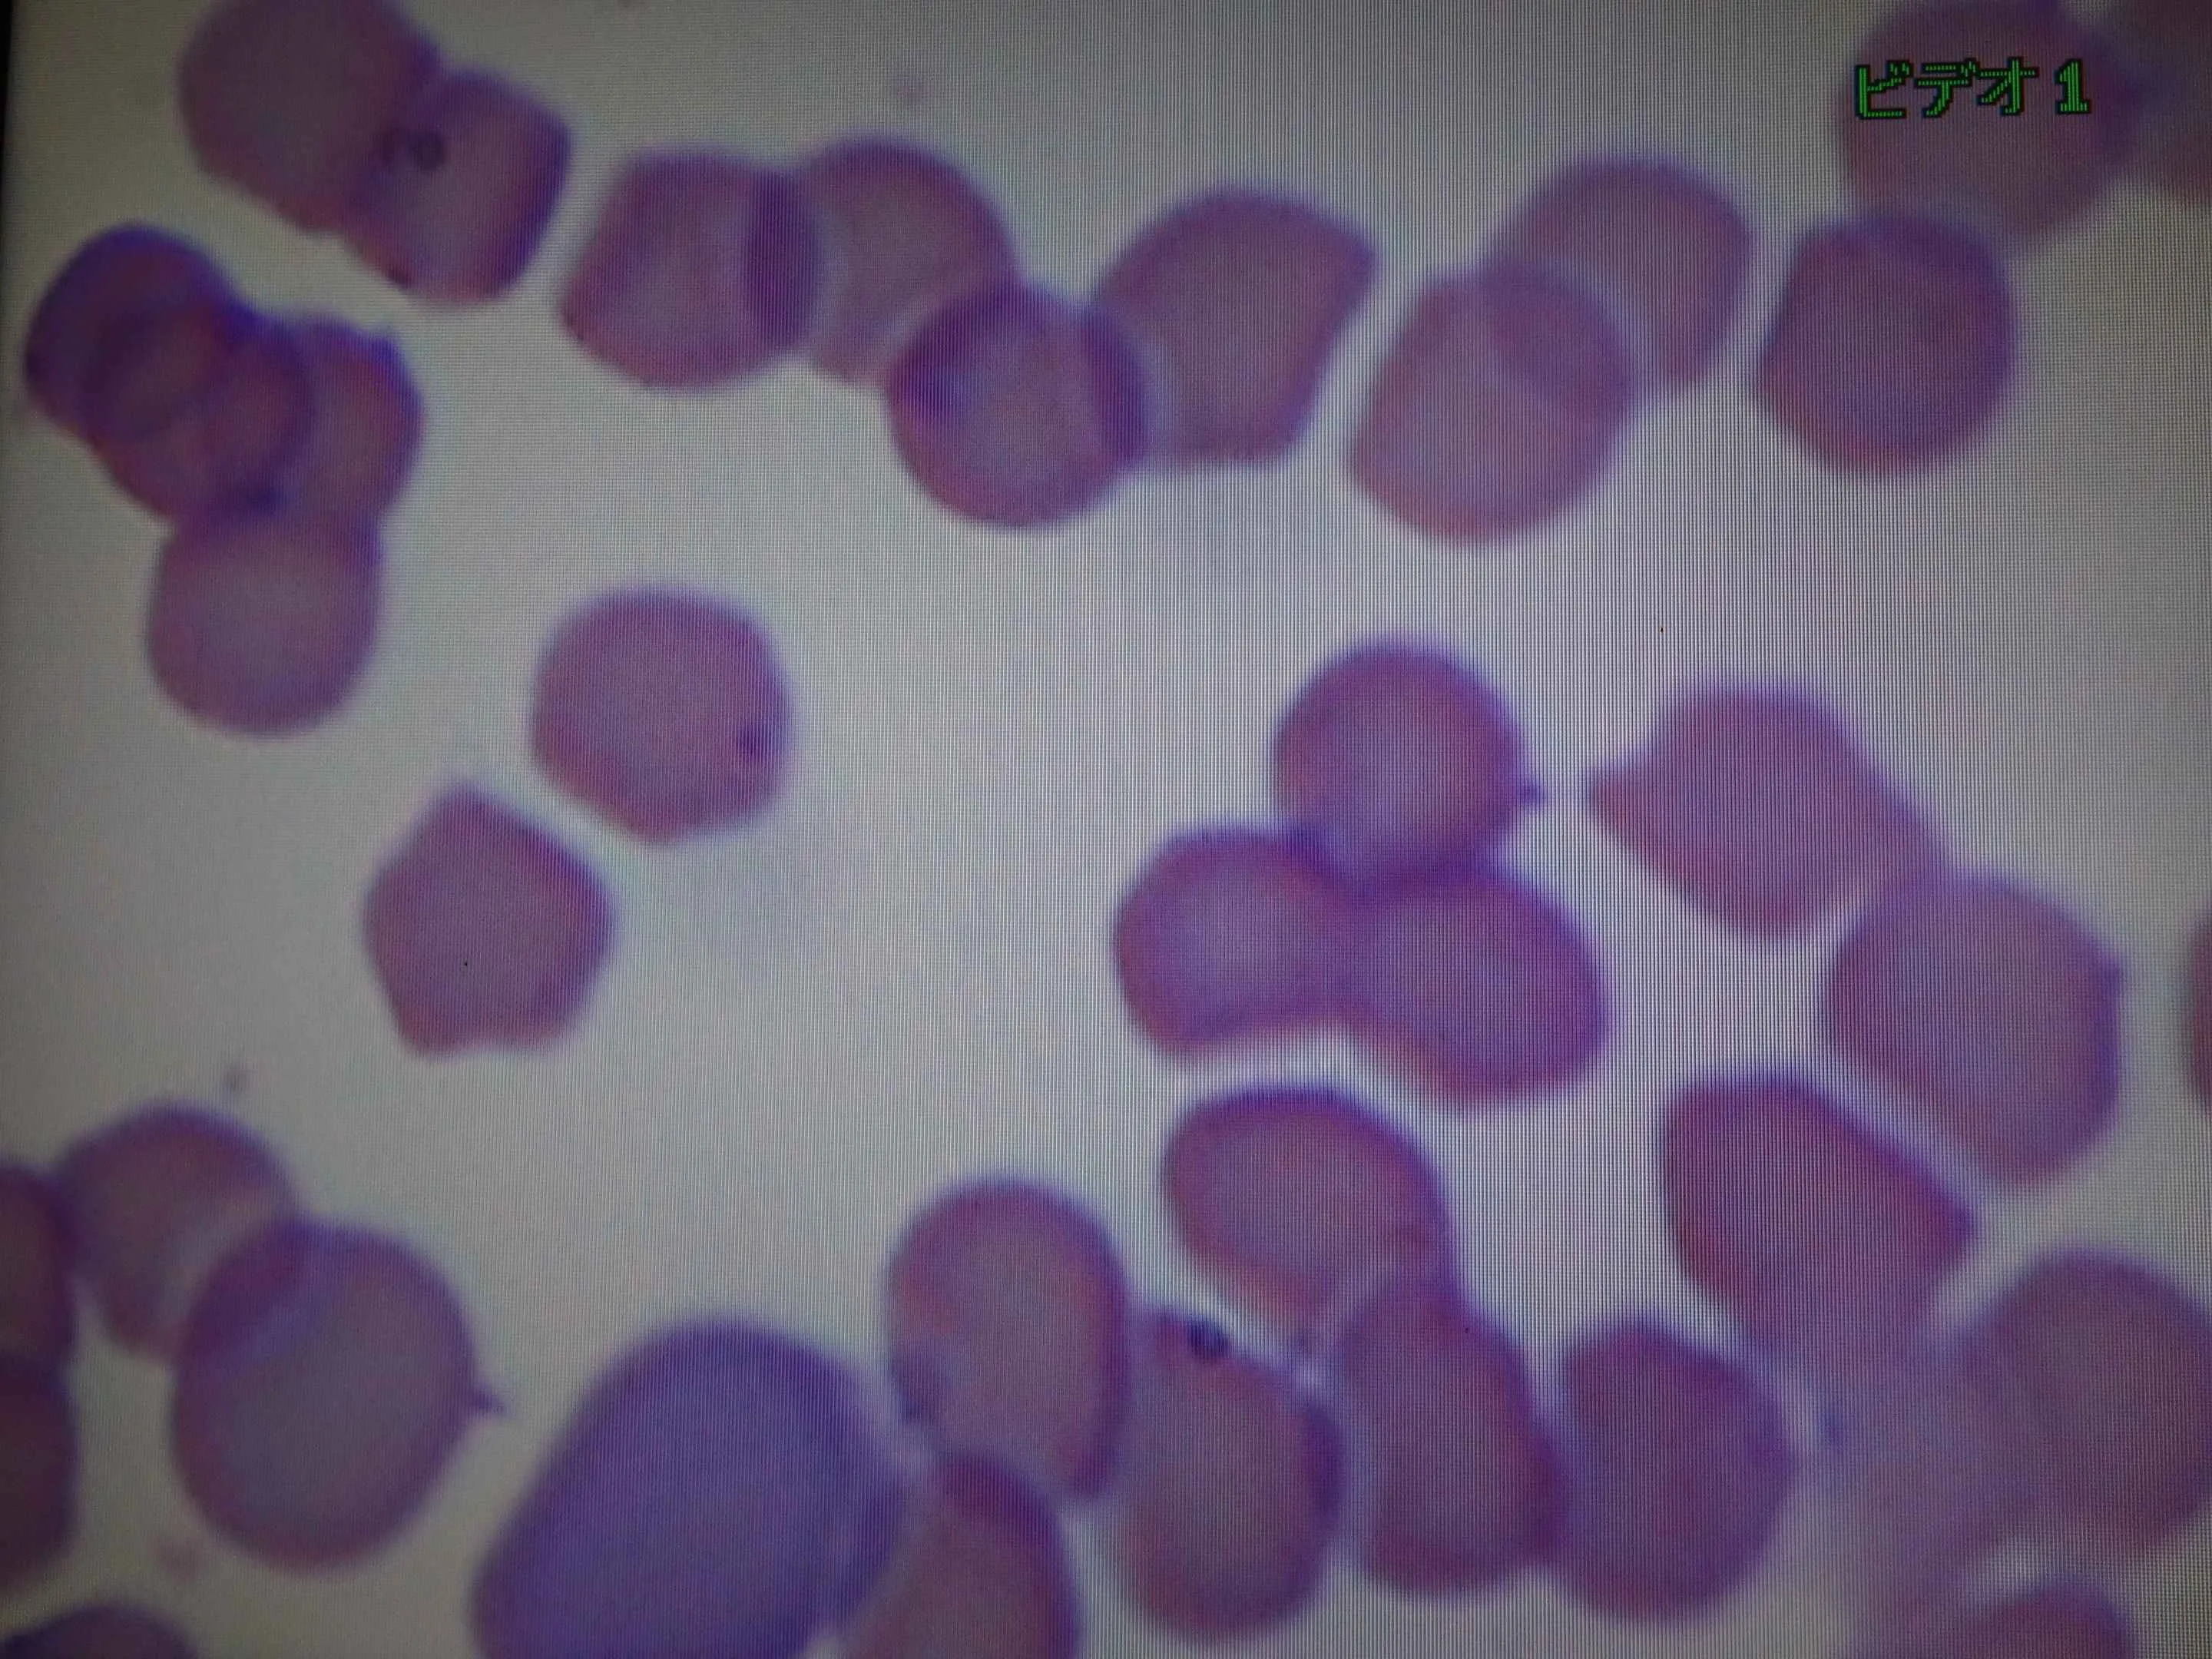
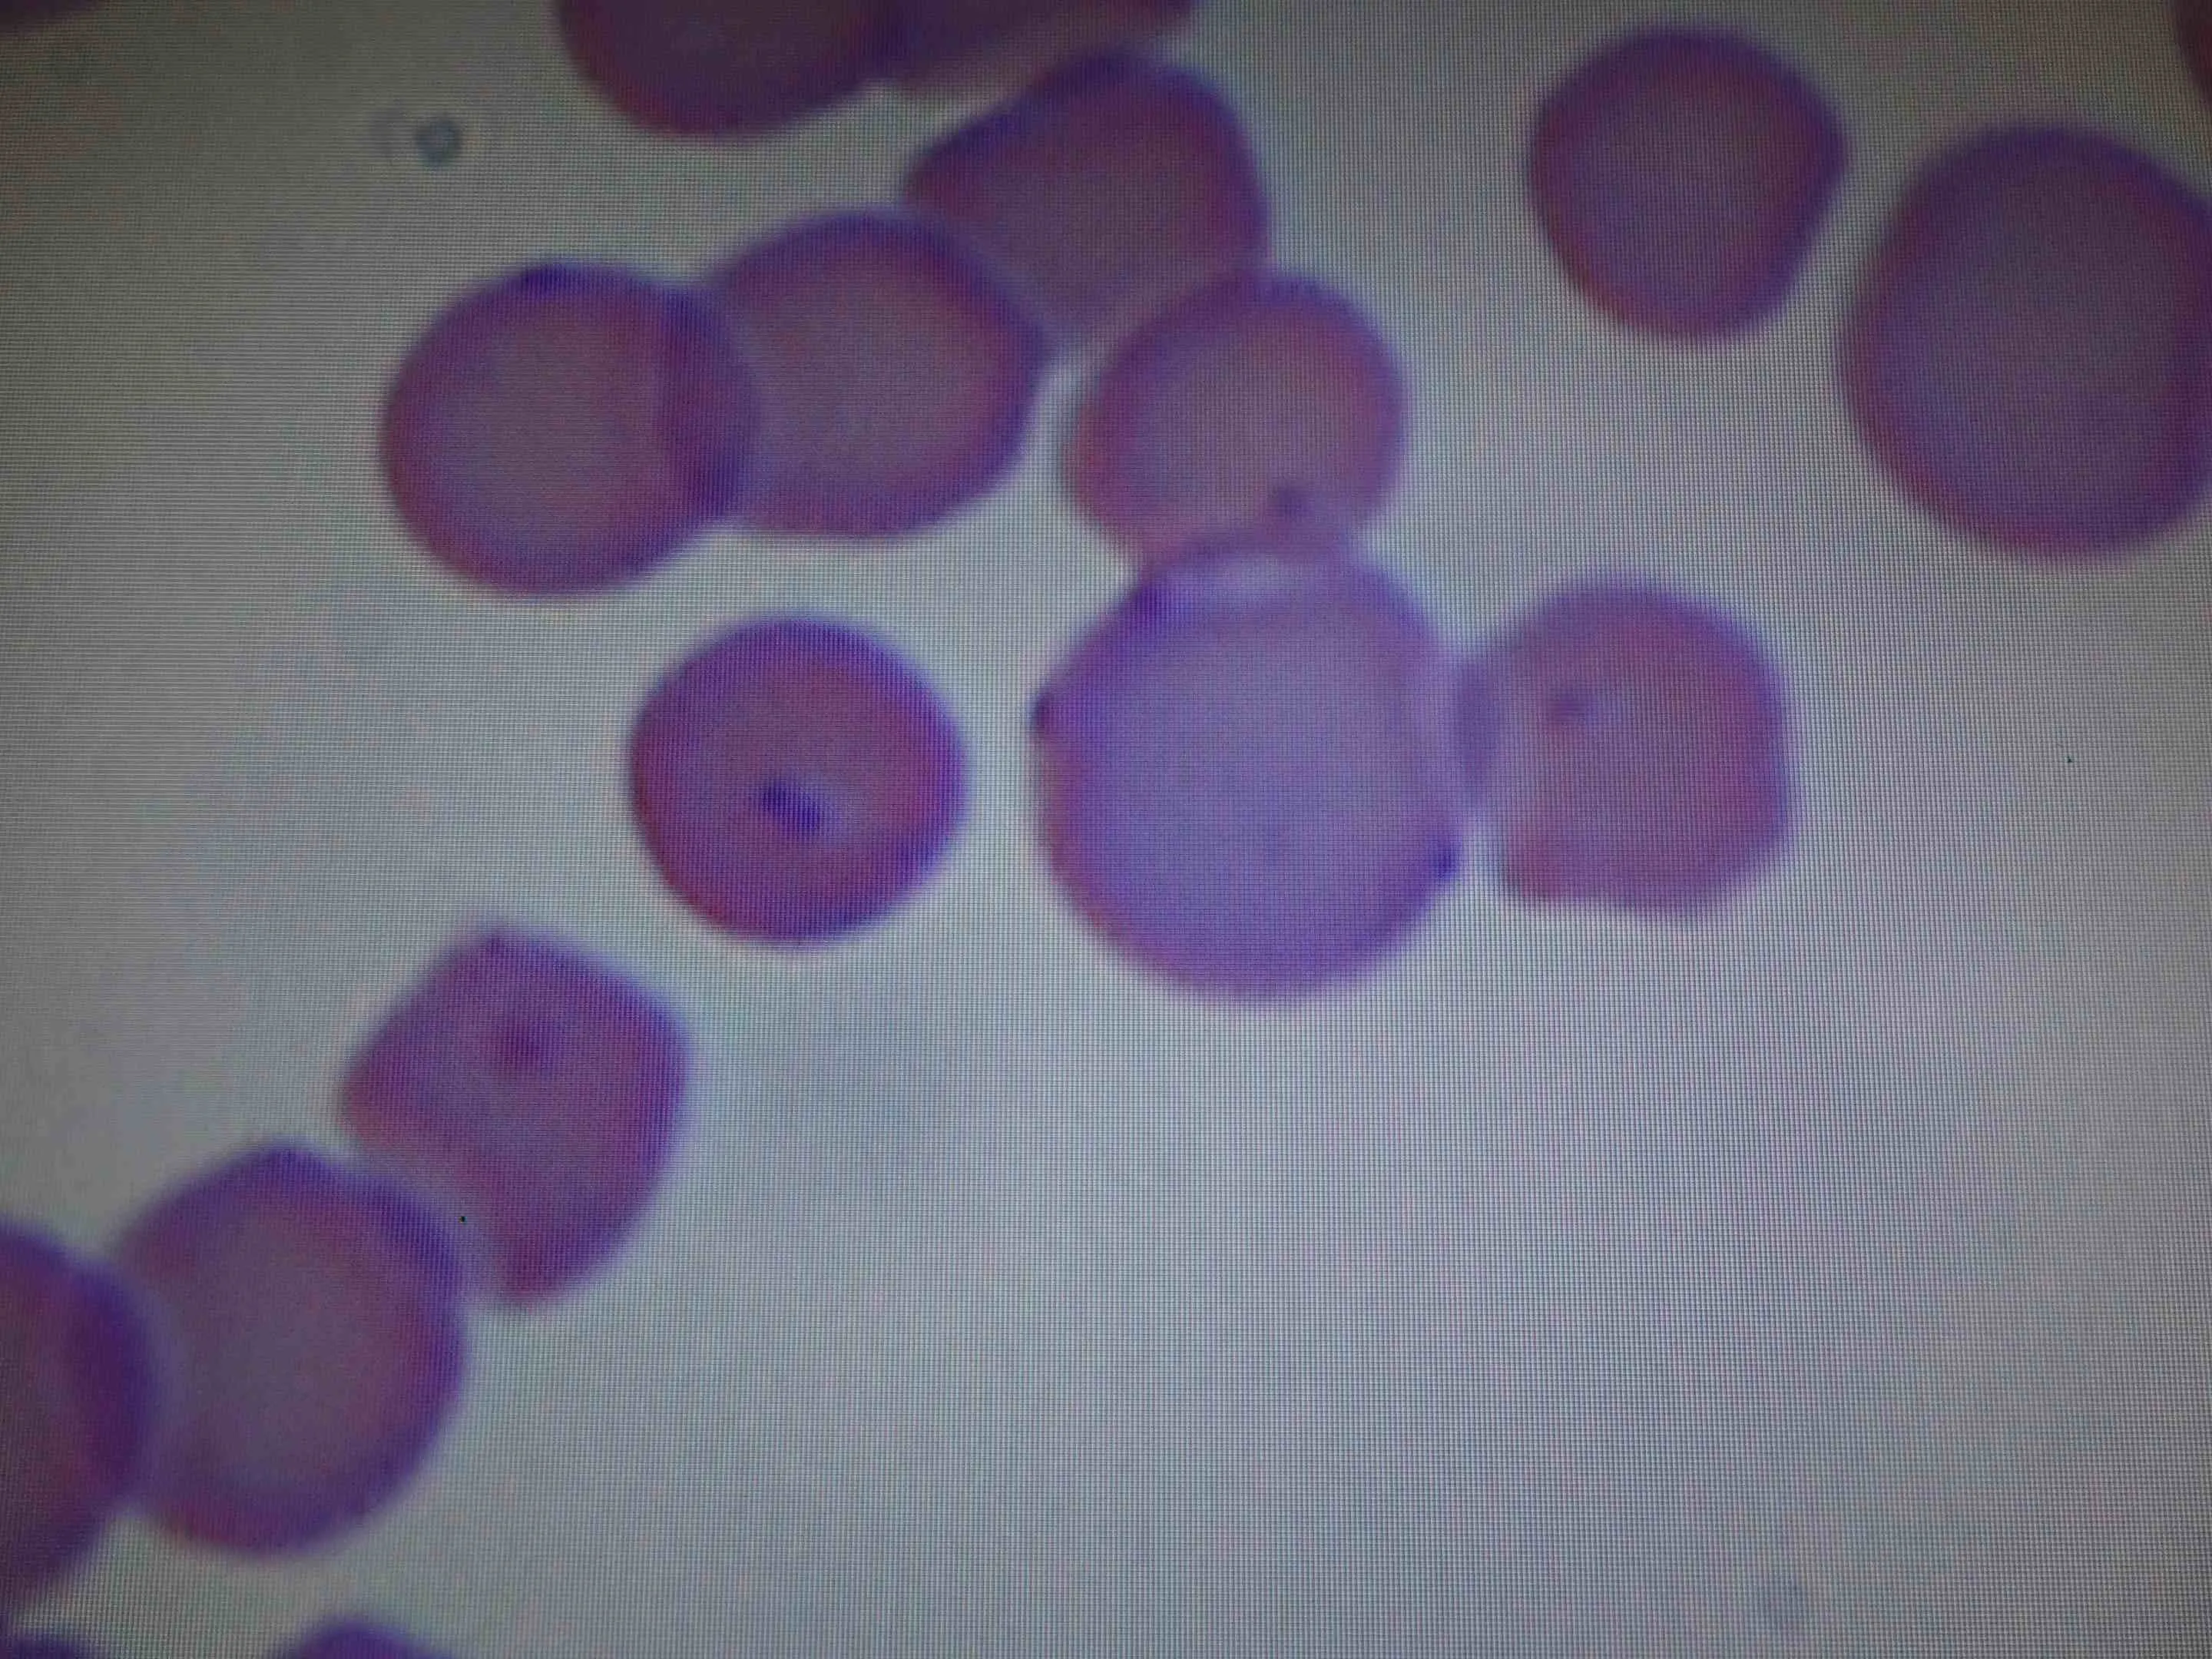

猫ヘモプラズマ症(旧ヘモバルトネラ症)
猫の飼い主様でこの名前を知る人はまだ少ないでしょう。
マイコプラズマが赤血球に寄生することで赤血球が破壊されて、貧血を発生す病気のことです。
以前、私が学生だった大昔は、この疾患の病原体はリケッチアの一種と考えられ、「ヘモバルトネラ症」と呼ばれていました。近年の研究の進歩、遺伝子解析によりマイコプラズマということが判明し呼称も変更されました。
診断では末梢血液の塗抹染色の鏡検により赤血球の膜状に小球菌様の寄生体(0.3〜0.8μm)を確認することができます。但し、形が特徴的でないので貧血時に出現する赤血球の構造物やごみ、染色液の夾雑物との鑑別は困難なため、確定診断はPCRという遺伝子診断が主流を占めてきております。
レアな病気ですが、精査すると発見されます。症状は発熱、元気消失、食欲不振、脱水、脾腫です。
本日来院した猫ちゃんの主訴は可視粘膜の蒼白と元気消失でした。血液検査を実施。赤血球数が458万、ヘモグロビン量(血色素)7.6g/dL、PCV(ヘマトクリット値)25.2%血小板数8万と中〜重程度の貧血。FIV(+)FeLV(−)でした。
塗抹染色標本で赤血球上に斑点を多数観察されました。ヘモプラズマ症はFIV、FeLV陽性の症例に多いとされていますので、まさにこの症例は本症を強く疑います。
主訴が貧血と元気消失の猫の場合、FIVやFeLVの検査、血液検査時に血液数やヘマトクリット値はルーチンワークですが、塗抹鏡検はあまり実施することが多くありません。ついついデーター重視で自らの手や眼を駆使する臨床検査は二の次になりがちです。忙しい時などは尚更。初診に初心忘るべからずですね。